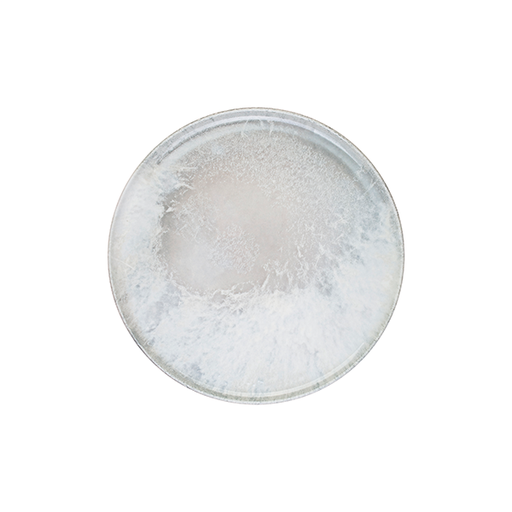
Surf Mesa Pizza Tabağı 31 cm

Surf
Markalar
₺ 105 + KDV
₺ 84 + KDV
%20
₺ 181 + KDV
₺ 145 + KDV
%20
₺ 577 + KDV
₺ 461 + KDV
%20
₺ 87 + KDV
₺ 70 + KDV
%20
₺ 133 + KDV
₺ 106 + KDV
%20
₺ 234 + KDV
₺ 187 + KDV
%20
₺ 155 + KDV
₺ 124 + KDV
%20
₺ 184 + KDV
₺ 147 + KDV
%20
₺ 284 + KDV
₺ 227 + KDV
%20
₺ 445 + KDV
₺ 356 + KDV
%20
₺ 264 + KDV
₺ 211 + KDV
%20
₺ 220 + KDV
₺ 176 + KDV
%20
₺ 373 + KDV
₺ 298 + KDV
%20
₺ 120 + KDV
₺ 96 + KDV
%20
₺ 242 + KDV
₺ 193 + KDV
%20
₺ 132 + KDV
₺ 106 + KDV
%20
₺ 506 + KDV
₺ 405 + KDV
%20
₺ 290 + KDV
₺ 232 + KDV
%20
₺ 120 + KDV
₺ 96 + KDV
%20
₺ 308 + KDV
₺ 246 + KDV
%20
₺ 304 + KDV
₺ 243 + KDV
%20
₺ 206 + KDV
₺ 165 + KDV
%20
₺ 287 + KDV
₺ 229 + KDV
%20
₺ 164 + KDV
₺ 131 + KDV
%20
₺ 89 + KDV
₺ 71 + KDV
%20
₺ 165 + KDV
₺ 132 + KDV
%20
₺ 103 + KDV
₺ 83 + KDV
%20
₺ 348 + KDV
₺ 278 + KDV
%20
₺ 640 + KDV
₺ 512 + KDV
%20
₺ 251 + KDV
₺ 200 + KDV
%20